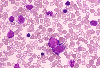

|    |

全登録症例数:225
全登録画像数:1755
全登録画像数:1755
白血病細胞の80%以上を単球系(単芽球、前単球、単球)が占め、顆粒球系は20%以下とされる。さらに単球系のうち単芽球が80%以上を占める場合を低分化型の単球性白血病(M5a)、80%未満を分化型の単球性白血...
(続きを読む) 白血病細胞の80%以上を単球系(単芽球、前単球、単球)が占め、顆粒球系は20%以下とされる。さらに単球系のうち単芽球が80%以上を占める場合を低分化型の単球性白血病(M5a)、80%未満を分化型の単球性白血病(M5b)に区分される。
M5aの形態学的特徴は、大型で核は円形から類円形、クロマチンは粗荒で明瞭な核小体を有する。細胞質の好塩基性は強く、舌状の突起を有しアズール顆粒は時に認める。
本例は、骨髄に増加する単球系は80%以上を占め、しかも単芽球が80%を超えるものであり、それらはPo染色が陰性、EST染色が強陽性でNaFに阻害されたことと表現型より単球系を支持することからAML-M5aと診断された。
(たたむ)
(続きを読む) 白血病細胞の80%以上を単球系(単芽球、前単球、単球)が占め、顆粒球系は20%以下とされる。さらに単球系のうち単芽球が80%以上を占める場合を低分化型の単球性白血病(M5a)、80%未満を分化型の単球性白血病(M5b)に区分される。
M5aの形態学的特徴は、大型で核は円形から類円形、クロマチンは粗荒で明瞭な核小体を有する。細胞質の好塩基性は強く、舌状の突起を有しアズール顆粒は時に認める。
本例は、骨髄に増加する単球系は80%以上を占め、しかも単芽球が80%を超えるものであり、それらはPo染色が陰性、EST染色が強陽性でNaFに阻害されたことと表現型より単球系を支持することからAML-M5aと診断された。
(たたむ)
■症例詳細データ
| FAB分類 | > 急性骨髄性白血病 (AML) > 単球性 (単球系が優位) > 低分化型 (M5a) |
|---|---|
| 性別 | 男 |
| 年齢 | 10-14 |
| 取得年代 | 2005-2009 |
| 主訴 | 微熱、白血球増加。 |
| 既往歴 | 特になし。 |
| 現病歴 | 左股間節痛、微熱、白血球増加を近医にて指摘され、精査のため当院へ紹介入院となった。 DIC(+) |
| 検査所見 | WBC 86,400/μl (芽球80%, 10/100w) RBC 468万/μl、Hb 12.5g/dl、Ht 38.9%、PLT 5.2万/μl MCV 83.1fl、MCH 26.7pg、MCHC 32.1%、 NCC 15.2万/μl、MgK 0/μl (芽球91%) LD 1,536IU/l、Fbg 112mg/dl、FDP 125.5μg/ml、D-ダイマー 26.2μg/ml |
| 末梢血所見 | 白血球著増(86,400/μl)にて芽球が80%みられた。 赤芽球もみられ、白赤芽球症を呈していた。 |
| 骨髄所見 | 正形成にて単球系の増加がみられ、芽球はANC中の91%みられた。単芽球は全単球の81%にみられ、単芽球を推測した。単芽球の一部に核形不整やアズール顆粒を有するものがみられた。 |
| 細胞化学所見 | 単球系はPO染色に陰性、プチレートEST染色に強陽性でNaFに阻害された。 |
| 形態診断 | 末梢血、骨髄で単芽球をはじめとする単球系の著増があり、骨髄で単芽球が80%以上(実際は81%)みられたこと、PO染色が陰性やNaF阻害EST染色の陽性より単芽球を支持するものと思われ、低分化型の単球性白血病(AML-M5a)を疑った。 |
| 免疫学的所見 | CD4・CD11b・CD11c・CD14・HLA-DR(+) |
| 分子生物学的所見 | 46,XY[20] |
| リンパ節所見 | 未施行。 |
| 臨床診断 | 骨髄に増加する単球系は、単芽球が80%を超えるものであり、表現型も単球系を支持することからAML-M5aと診断された。染色体は正常核型であった。 |